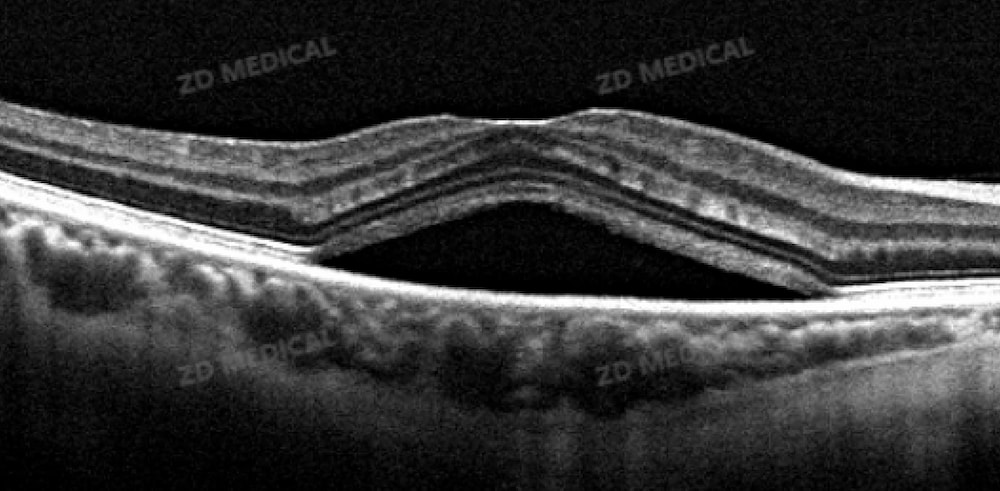

Enfermedades de la retina como la retinopatía diabética (RD) y la degeneración macular relacionada con la edad (DMAE) se han convertido en las principales causas de ceguera irreversible en China, y la mayoría de los pacientes han perdido la mejor oportunidad de intervención al presentar síntomas evidentes. Según las estadísticas, más de 250 millones de personas en todo el mundo padecen discapacidad visual, y casi la mitad puede evitarla mediante una intervención temprana. Sin embargo, las limitaciones de los métodos de examen tradicionales han hecho que muchos pacientes pierdan la mejor oportunidad de tratamiento. En esta carrera contra la oscuridad, ZD Medical Las soluciones precisas de diagnóstico y tratamiento centradas en los escáneres de tomografía de coherencia óptica (OCT) se están convirtiendo en una fuerza clave en la prevención de la ceguera.
El fondo de ojo, como núcleo central de la transmisión de señales visuales, a menudo sirve como una "alerta temprana" de ceguera debido a sus lesiones microscópicas. Los métodos de examen tradicionales dificultan la captura de los cambios sutiles entre las capas de la retina. Sin embargo, la tecnología OCT ha logrado un gran avance gracias a su ventaja única de "biopsia óptica": mediante el principio de interferencia de luz coherente débil, puede reconstruir imágenes bidimensionales y tridimensionales del fondo de ojo con una profundidad milimétrica y una resolución micrométrica. Presenta con claridad marcadores clave de lesiones, como el derrame intrarretiniano (FIR) y el derrame subretiniano (FRS).

La importancia del Día Internacional de los Ciegos no solo reside en cuidar a quienes han perdido la vista, sino también en salvaguardar la salud visual que aún existe. "Liderando con la tecnología y salvaguardando la luz", el valor de la OCT nunca se ha limitado a la obtención de imágenes precisas; más bien, reside en consolidar el concepto de "detección e intervención tempranas" para la prevención de la ceguera mediante la popularización de la tecnología. En este Día Internacional de los Ciegos, creemos firmemente que cuando cada ZD Medical El dispositivo OCT comienza a funcionar y está cubriendo la oscuridad de una familia. Cada informe preciso generado da esperanza a los pacientes. Proteger la luz nunca es un golpe de suerte, sino una respuesta conjunta de tecnología y responsabilidad. Zhiding Medical seguirá tomando la innovación tecnológica como pluma y las necesidades clínicas como tinta, y avanzará con firmeza en la prevención de la ceguera.
También bienvenidos a
Contáctanos
, somos
ZD Medical Inc
.
Teléfono: +86-187 9586 9515
Correo electrónico :
sales@zd-med.com
WhatsApp/Móvil: +86-187 9586 9515